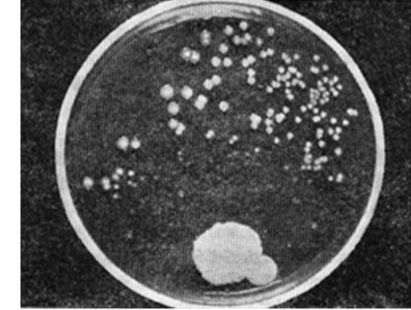
超级细菌在伊拉克战场肆虐 30年后或死上千万人

伊拉克细菌

伊拉克细菌
图片尺寸199x138
超级细菌在伊拉克战场肆虐 30年后或死上千万人
图片尺寸411x310
这种黏糊糊的细菌减肥竟有如此威力nature子刊
图片尺寸1065x593
一种清洁牙齿的细菌(图)
图片尺寸750x562
超级细菌是什么
图片尺寸300x299
【实用】致死率30%的细菌,有可能就藏在你家的冰箱里!
图片尺寸640x480
双重恐怖 神秘「下刚果病毒」=伊波拉 疯狗症!
图片尺寸450x450
太恐怖了,看看显微镜下手上的细菌,你还敢饭前不洗手?
图片尺寸661x600
科研人员发现了抗生素抗性基因
图片尺寸640x461
可怕这种细菌不仅危及人们健康还可在极端情况下存活
图片尺寸686x816
26种玛芬蛋糕疑遭细菌污染,costco,沃尔玛,7-11等多家超市有售!
图片尺寸720x440
感染了伊拉克细菌的美国病人
图片尺寸569x401
警惕!复工后,在外喝水要小心了
图片尺寸390x293
大部分抗生素奈何不了的"伊拉克细菌"被噬菌体一击致命
图片尺寸731x432
人类肚脐含有67种不同细菌
图片尺寸550x366
一位上海教授说了大实话:它在伊拉克战场肆虐,30年后或杀死上千万人!
图片尺寸907x536
嗜军团菌细菌嗜肺军团菌军团菌病病原嗜肺军团菌嗜肺军团菌水中军团菌
图片尺寸533x300
显微镜下的伊波拉病毒
图片尺寸1200x900
看看这是什么细菌,在伊红美兰培养基,室温培养.
图片尺寸640x480
明早起,别一开水龙头就刷牙洗脸了
图片尺寸640x406